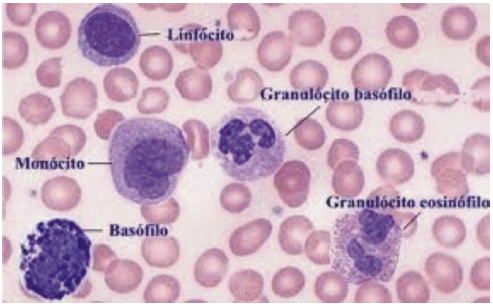
enunciado 400949-1

Observe a imagem que mostra um conjunto de células que faz parte de um dos sistemas biológicos humanos.
Disponível em: http://www.sobiologia.com.br/conteudos/Corpo/Circulacao4.php
As células apresentadas fazem parte de um tipo tecido animal.
Em relação ao tipo de tecido animal representado, assinale a alternativa CORRETA.